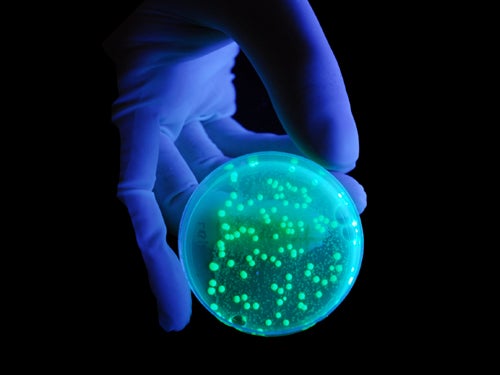

simple electric circuits diagrams
Download QElectroTech 0.80c / 0.90 dev+git7141-1. 9 Pictures about Download QElectroTech 0.80c / 0.90 dev+git7141-1 : Electrical Circuits - Presentation Physics, Electrical Circuits - Presentation Physics and also Series And Parallel Circuits For Kids | Kids Matttroy.
Download QElectroTech 0.80c / 0.90 Dev+git7141-1
 www.softpedia.com
www.softpedia.com
portable screenshots dev 80c softpedia
Electrical Symbols And Diagrams Questions Answers | Electrical Academia
 electricalacademia.com
electricalacademia.com
Series And Parallel Circuits For Kids | Kids Matttroy
 kids.matttroy.net
kids.matttroy.net
parallel circuits series physics lab building lesson study
10 Simple Electric Circuits With Diagrams
 www.brighthubengineering.com
www.brighthubengineering.com
circuit simple circuits diagram electrical electric current diagrams transformer motor phase single connected ammeter commercial
Ultraviolet Torch : 13 Steps (with Pictures) - Instructables
www.instructables.com
www.instructables.com
torch ultravioleta linterna askix
Electrical Circuits - Presentation Physics
.PNG) www.sliderbase.com
www.sliderbase.com
circuit diagram circuits electrical simple physics
Arduino Projects Under Repository-circuits -46058- : Next.gr
 www.next.gr
www.next.gr
arduino projects circuit embedded diy gr above computer
Electrical Circuits - Presentation Physics
.PNG) www.sliderbase.com
www.sliderbase.com
series circuit circuits types electrical parallel physics revised there slideshare
Grade 6: Circuits - YouTube
 www.youtube.com
www.youtube.com
grade circuits
Electrical symbols and diagrams questions answers. Parallel circuits series physics lab building lesson study. Series circuit circuits types electrical parallel physics revised there slideshare